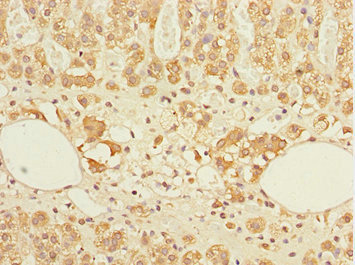

GABARAPL1 Antibody
-
中文名稱:GABARAPL1兔多克隆抗體
-
貨號:CSB-PA861986DSR2HU
-
規格:¥440
-
圖片:
-
其他:
產品詳情
-
產品名稱:Rabbit anti-Homo sapiens (Human) GABARAPL1 Polyclonal antibody
-
Uniprot No.:
-
基因名:
-
別名:APG8 like antibody; APG8L antibody; ATG8 antibody; ATG8B antibody; ATG8L antibody; Early estrogen regulated protein antibody; Early estrogen-regulated protein antibody; GABA antibody; GABA(A) receptor associated protein like 1 antibody; GABA(A) receptor-associated protein-like 1 antibody; GABARAPL1 a antibody; GABARAPL1 antibody; Gamma aminobutyric acid receptor associated protein like 1 antibody; Gamma-aminobutyric acid receptor-associated protein-like 1 antibody; GBRL1_HUMAN antibody; GEC 1 antibody; GEC-1 antibody; GEC1 antibody; Glandular epithelial cell protein 1 antibody
-
宿主:Rabbit
-
反應種屬:Human
-
免疫原:Recombinant Human Gamma-aminobutyric acid receptor-associated protein-like 1 protein (1-117AA)
-
免疫原種屬:Homo sapiens (Human)
-
標記方式:Non-conjugated
-
克隆類型:Polyclonal
-
抗體亞型:IgG
-
純化方式:Antigen Affinity Purified
-
濃度:It differs from different batches. Please contact us to confirm it.
-
保存緩沖液:PBS with 0.02% sodium azide, 50% glycerol, pH7.3.
-
產品提供形式:Liquid
-
應用范圍:ELISA, IHC
-
推薦稀釋比:
Application Recommended Dilution IHC 1:20-1:200 -
Protocols:
-
儲存條件:Upon receipt, store at -20°C or -80°C. Avoid repeated freeze.
-
貨期:Basically, we can dispatch the products out in 1-3 working days after receiving your orders. Delivery time maybe differs from different purchasing way or location, please kindly consult your local distributors for specific delivery time.
-
用途:For Research Use Only. Not for use in diagnostic or therapeutic procedures.
相關產品
靶點詳情
-
功能:Ubiquitin-like modifier that increases cell-surface expression of kappa-type opioid receptor through facilitating anterograde intracellular trafficking of the receptor. Involved in formation of autophagosomal vacuoles. While LC3s are involved in elongation of the phagophore membrane, the GABARAP/GATE-16 subfamily is essential for a later stage in autophagosome maturation. Through its interaction with the reticulophagy receptor TEX264, participates in the remodeling of subdomains of the endoplasmic reticulum into autophagosomes upon nutrient stress, which then fuse with lysosomes for endoplasmic reticulum turnover.
-
基因功能參考文獻:
- these results indicate that miR-195 regulates cell proliferation, migration, angiogenesis and autophagy of hEPCs by targeting GABARAPL1 PMID: 27623937
- Our data demonstrated that a specific decrease of GABARAPL1 expression in breast cancers was associated with both DNA methylation and histone deacetylation and that CREB-1 recruitment on GABARAPL1 PMID: 26474850
- Androgen deprivation downregulates Gabarapl1 in an AR dependent manner, resulting in the increase of autophagy flux PMID: 26050226
- GABARAPL1 plays an important role in cell proliferation, invasion, and autophagic flux, as well as in mitochondrial homeostasis and cellular metabolic programs in a breast cancer cell line. PMID: 24879149
- Kaplan-Meier survival analysis showed a significant association between low GABARAPL1 expression and poor prognosis of HCC patients. PMID: 24647565
- Data demonstrate that HSP90 interacts and protects GABARAPL1 from its degradation by the proteasome. PMID: 22120110
- analysis of specific functions of GABARAPL1 [review] PMID: 21597319
- Atg8 interacting motif (AIM) in Stbd1 is necessary for GABARAPL1 binding. PMID: 21893048
- Results indicate that the presence of a tryptophan residue in the LIR motif increases the binding affinity of GABARAPL-1/NBR1-LIR complex. PMID: 21620860
- Gabarapl1 mRNA expression in breast tumours is a good indicator of the risk of recurrence, specifically in lymph nodes positive patients. PMID: 20197771
- GEC1 interacts with the kappa opioid receptor and enhances expression of the receptor PMID: 16431922
- GEC1-kappa opioid receptor binding involves hydrophobic interactions: GEC1 has chaperone-like effect. PMID: 19001416
- Caspase cleavage of Atg4D stimulates GABARAP-L1 processing and triggers mitochondrial targeting and apoptosis. PMID: 19549685
顯示更多
收起更多
-
亞細胞定位:Cytoplasmic vesicle, autophagosome. Cytoplasmic vesicle membrane; Lipid-anchor. Cytoplasm, cytoskeleton. Endoplasmic reticulum. Golgi apparatus.
-
蛋白家族:ATG8 family
-
組織特異性:Ubiquitous. Expressed at very high levels in the brain, heart, peripheral blood leukocytes, liver, kidney, placenta and skeletal muscle. Expressed at very low levels in thymus and small intestine. In the brain, expression is particularly intense in motone
-
數據庫鏈接:
Most popular with customers
-
-
YWHAB Recombinant Monoclonal Antibody
Applications: ELISA, WB, IHC, IF, FC
Species Reactivity: Human, Mouse, Rat
-
Phospho-YAP1 (S127) Recombinant Monoclonal Antibody
Applications: ELISA, WB, IHC
Species Reactivity: Human
-
-
-
-
-